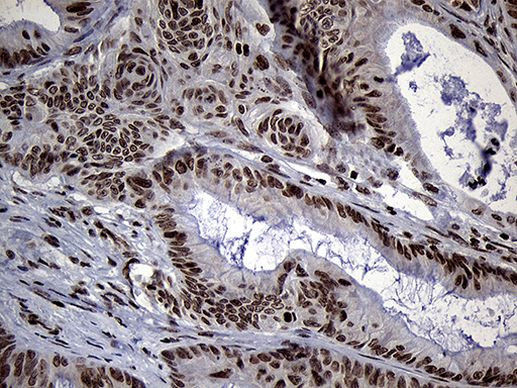
SPANXB1 Antibody in Immunohistochemistry (Paraffin) (IHC (P))

Search
Invitrogen
SPANXB1 Monoclonal Antibody (OTI6G2)
{{$productOrderCtrl.translations['antibody.pdp.commerceCard.promotion.promotions']}}
{{$productOrderCtrl.translations['antibody.pdp.commerceCard.promotion.viewpromo']}}
{{$productOrderCtrl.translations['antibody.pdp.commerceCard.promotion.promocode']}}: {{promo.promoCode}} {{promo.promoTitle}} {{promo.promoDescription}}. {{$productOrderCtrl.translations['antibody.pdp.commerceCard.promotion.learnmore']}}
图: 1 / 7
SPANXB1 Antibody (MA5-27457) in IHC (P)







Please note: We are reviewing Western blot images included in the antibody testing data in our catalog, including those provided by third parties. Unless expressly labeled or annotated as “raw-unedited”, Western blot images included in the antibody testing data in our catalog may have been edited, optimized or otherwise adjusted for presentation.
产品信息
MA5-27457
种属反应
宿主/亚型
分类
类型
克隆号
抗原
偶联物
形式
浓度
规格
纯化类型
保存液
内含物
保存条件
运输条件
RRID
靶标信息
Temporally regulated transcription and translation of several testis-specific genes is required to initiate the series of molecular and morphological changes in the male germ cell lineage necessary for the formation of mature spermatozoa. This gene is a member of the SPANX family of cancer/testis-associated genes, which are located in a cluster on chromosome X. The SPANX genes encode differentially expressed testis-specific proteins that localize to various subcellular compartments. This particular gene maps to chromosome X in a head-to-tail orientation with SPANX family member B2, which appears to be a duplication of the B1 locus. The SPANXB genes are unique members of this gene family, since they contain an additional 18 nt in their coding region compared to the majority of family members. Although the protein encoded by this gene contains consensus nuclear localization signals, the major site for subcellular localization of expressed protein is in the cytoplasmic droplets of ejaculated spermatozoa. This protein provides a biochemical marker for studying the unique structures in spermatazoa, while attempting to further define its role in spermatogenesis.
仅用于科研。不用于诊断过程。未经明确授权不得转售。
篇参考文献 (0)
生物信息学
蛋白别名: Cancer/testis antigen 11.2; CT11.2; Nuclear-associated protein SPAN-Xb; SPANX family member B1; SPANX family member F1; SPANX-B; Sperm protein associated with the nucleus on the X chromosome B1
基因别名: SPANXB; SPANXB1; SPANXB2; SPANXF1
Entrez Gene ID: (Human) 728695